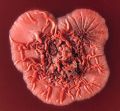
2021年7月26日 (一) 18:41的版本的缩略图

文件:Penicillium marneffei colony.jpg
来自医学百科
Penicillium_marneffei_colony.jpg (541 × 500像素,文件大小:88 KB,MIME类型:image/jpeg)
文件历史
单击某个日期/时间查看对应时刻的文件。
| 日期/时间 | 缩略图 | 大小 | 用户 | 备注 | |
|---|---|---|---|---|---|
| 当前 | 2021年7月26日 (一) 18:41 | | 541 × 500(88 KB) | 77921020(讨论 | 贡献) | Uploaded with SimpleBatchUpload |
您不可以覆盖此文件。
文件用途
以下页面使用本文件:
